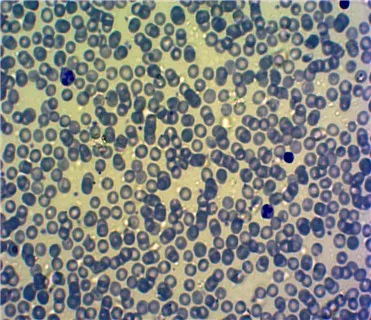

Медицинская микробиология гематология человека приготовленные слайды размазка
- Категории: Другие учебные ресурсы >>>
- Поставщик: Henan,Yulin,Edu.,Project,Co.,Ltd.
Поделиться:
Описание и отзывы
Характеристики
Product Description

Medical Science Microbiology Human Hematology Prepared Slides Blood Smear
Our slides come in set or individual, placed in slide storage boxes and are fully labelled,using fresh material.
Well-distribued coloration, HE,India ink stain,Alcohol magenta,Hematoxylin staining .
Code | YULIN Description |
YCG020010 | Epidermis al cells of Cynops orientalis W.M. |
YCG020020 | Epithelial cells of small intestine sec. |
YCG020030 | Blood of Bufo bufo smear |
YCG020040 | Blood of Human smear(Wright's stain) |
YCG020050 | Blood of Human smear( stained with Giemsa) |
YCG020060 | Nerve cells from spinal cord smear |
YCG020070 | Sperm of Mouse smear |
YCG020080 | Spinal ganglion sec.(show Golgi body)(silver stain) |
YCG020090 | Liver sec.(show mitochondria ) |
YCG020100 | Liver sec.(show glycogen)(PAS) |
YCG020110 | Liver sec.(show DNA)(Feulgen) |
YCG020120 | Kidney sec.(show mitochondria) |
YCG020130 | Nerve cell smear(Nissl body)toluidine blue |
YCG020130 | Uterus of Parascaris equorum sec.(show centriole) |
YCG020140 | Mitosis of animal sec.(Parascaris equorum ) |
YMI040240 | Agrobacterium tumefaciens smear |
YMI040250 | Bacillis cereus smear |
YMI040260 | Proteus vulgaris smear |
YMI040270 | Acetobacter aceti smear |
YMI040280 | Nitrobocter smear |
YMI040300 | phototrophic bacteria smear. |
YMI040320 | Salmonella typhi smear |
YMI040330 | Azotobacter of horsebean root nodule smear |
YMI040350 | Vibrio cholerae |
YMI040370 | Bacillus anthraci |
YMI040380 | yersinia pestis |
YMI040390 | bifidobacterium |
YMI040400 | propionibacterium |
YMI040410 | Lactobacillus botulinum |
YMI040420 | campylobacter jejuni |
Details Images
Production Pocess




Packing & Delivery




Our Company
Our company specializes in manufacturing more than 3200 kinds of prepared mocroscope slides (including botany zoology, histology, pathology, embryology, Microscope, slides), microscope glass slides, coverslips. Microscope accessories, biological specimens, teaching models experiment materials, lab educational instruments, teaching wall charts, books, basketbals, football. volleyballs.

FAQ
1:How long you can fulfill the order normally? |
Usually we will take 3-15 days to produce the new slides,which is all based on the quality first. |
2:What is your minimum order quantity? |
Our MOQ is 1 set as usual.It will be more cheaper if you order more. |
3:How long the transportation take? |
The time depends on the delivery method.3-7 working days normally. |
4:What is the transportation? |
International express for small order. Air or sea transportation for big order. |
5:What is the payment terms and payment method you can accept? |
T/T,Western union,Money gram,Master card,Escrow,etc. |
6:Can you supply me the samples? |
Yes, but the samples should be charged,we will return the sample cost after you make the firm order. |
7:Can you do OEM&ODM for me? |
Yes, we offer OEM&ODM service. |
Related Products
Contact Us
We are a factory of all kinds of prepared microscope slides , microscopes , microscope slides and cover slips , teaching and medical models , and many other kinds of educational products , any demands you have , please contact me freely .
Waiting for your early reply
Best Regards
Henan Yulin Edu. Project Co., Ltd.
Cathy Wang Export manager
Email: cathywang@hnylju.cn or sales@yulinedu1958.com
Wechat: 18637306387
trademanager: hnyljy
Skype: jessy-zhang0715
Phone: 0086-13503800666
QQ: 2469484693
Website: http://www.yulinedu1958.com/
http://hnyljy.en.alibaba.com/
Waiting for your early reply
Best Regards
Henan Yulin Edu. Project Co., Ltd.
Cathy Wang Export manager
Email: cathywang@hnylju.cn or sales@yulinedu1958.com
Wechat: 18637306387
trademanager: hnyljy
Skype: jessy-zhang0715
Phone: 0086-13503800666
QQ: 2469484693
Website: http://www.yulinedu1958.com/
http://hnyljy.en.alibaba.com/






















